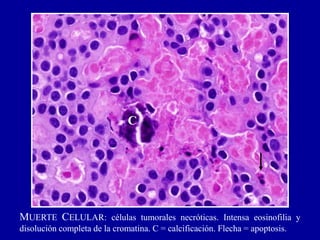
MUERTE CELULAR: células tumorales necróticas. Intensa eosinofilia y
disolución completa de la cromatina. C = calcificación. Flecha = apoptosis.
C

El documento detalla la biopatología de la muerte celular, diferenciando entre muerte celular accidental (oncosis) y muerte celular programada (apoptosis). Se abordan los tipos de necrosis, sus mecanismos, y los cambios morfológicos asociados, así como las implicaciones clínicas del daño celular y su diagnóstico. También se menciona el impacto del paracetamol en la hepatotoxicidad y el papel del calcio en la degeneración celular.